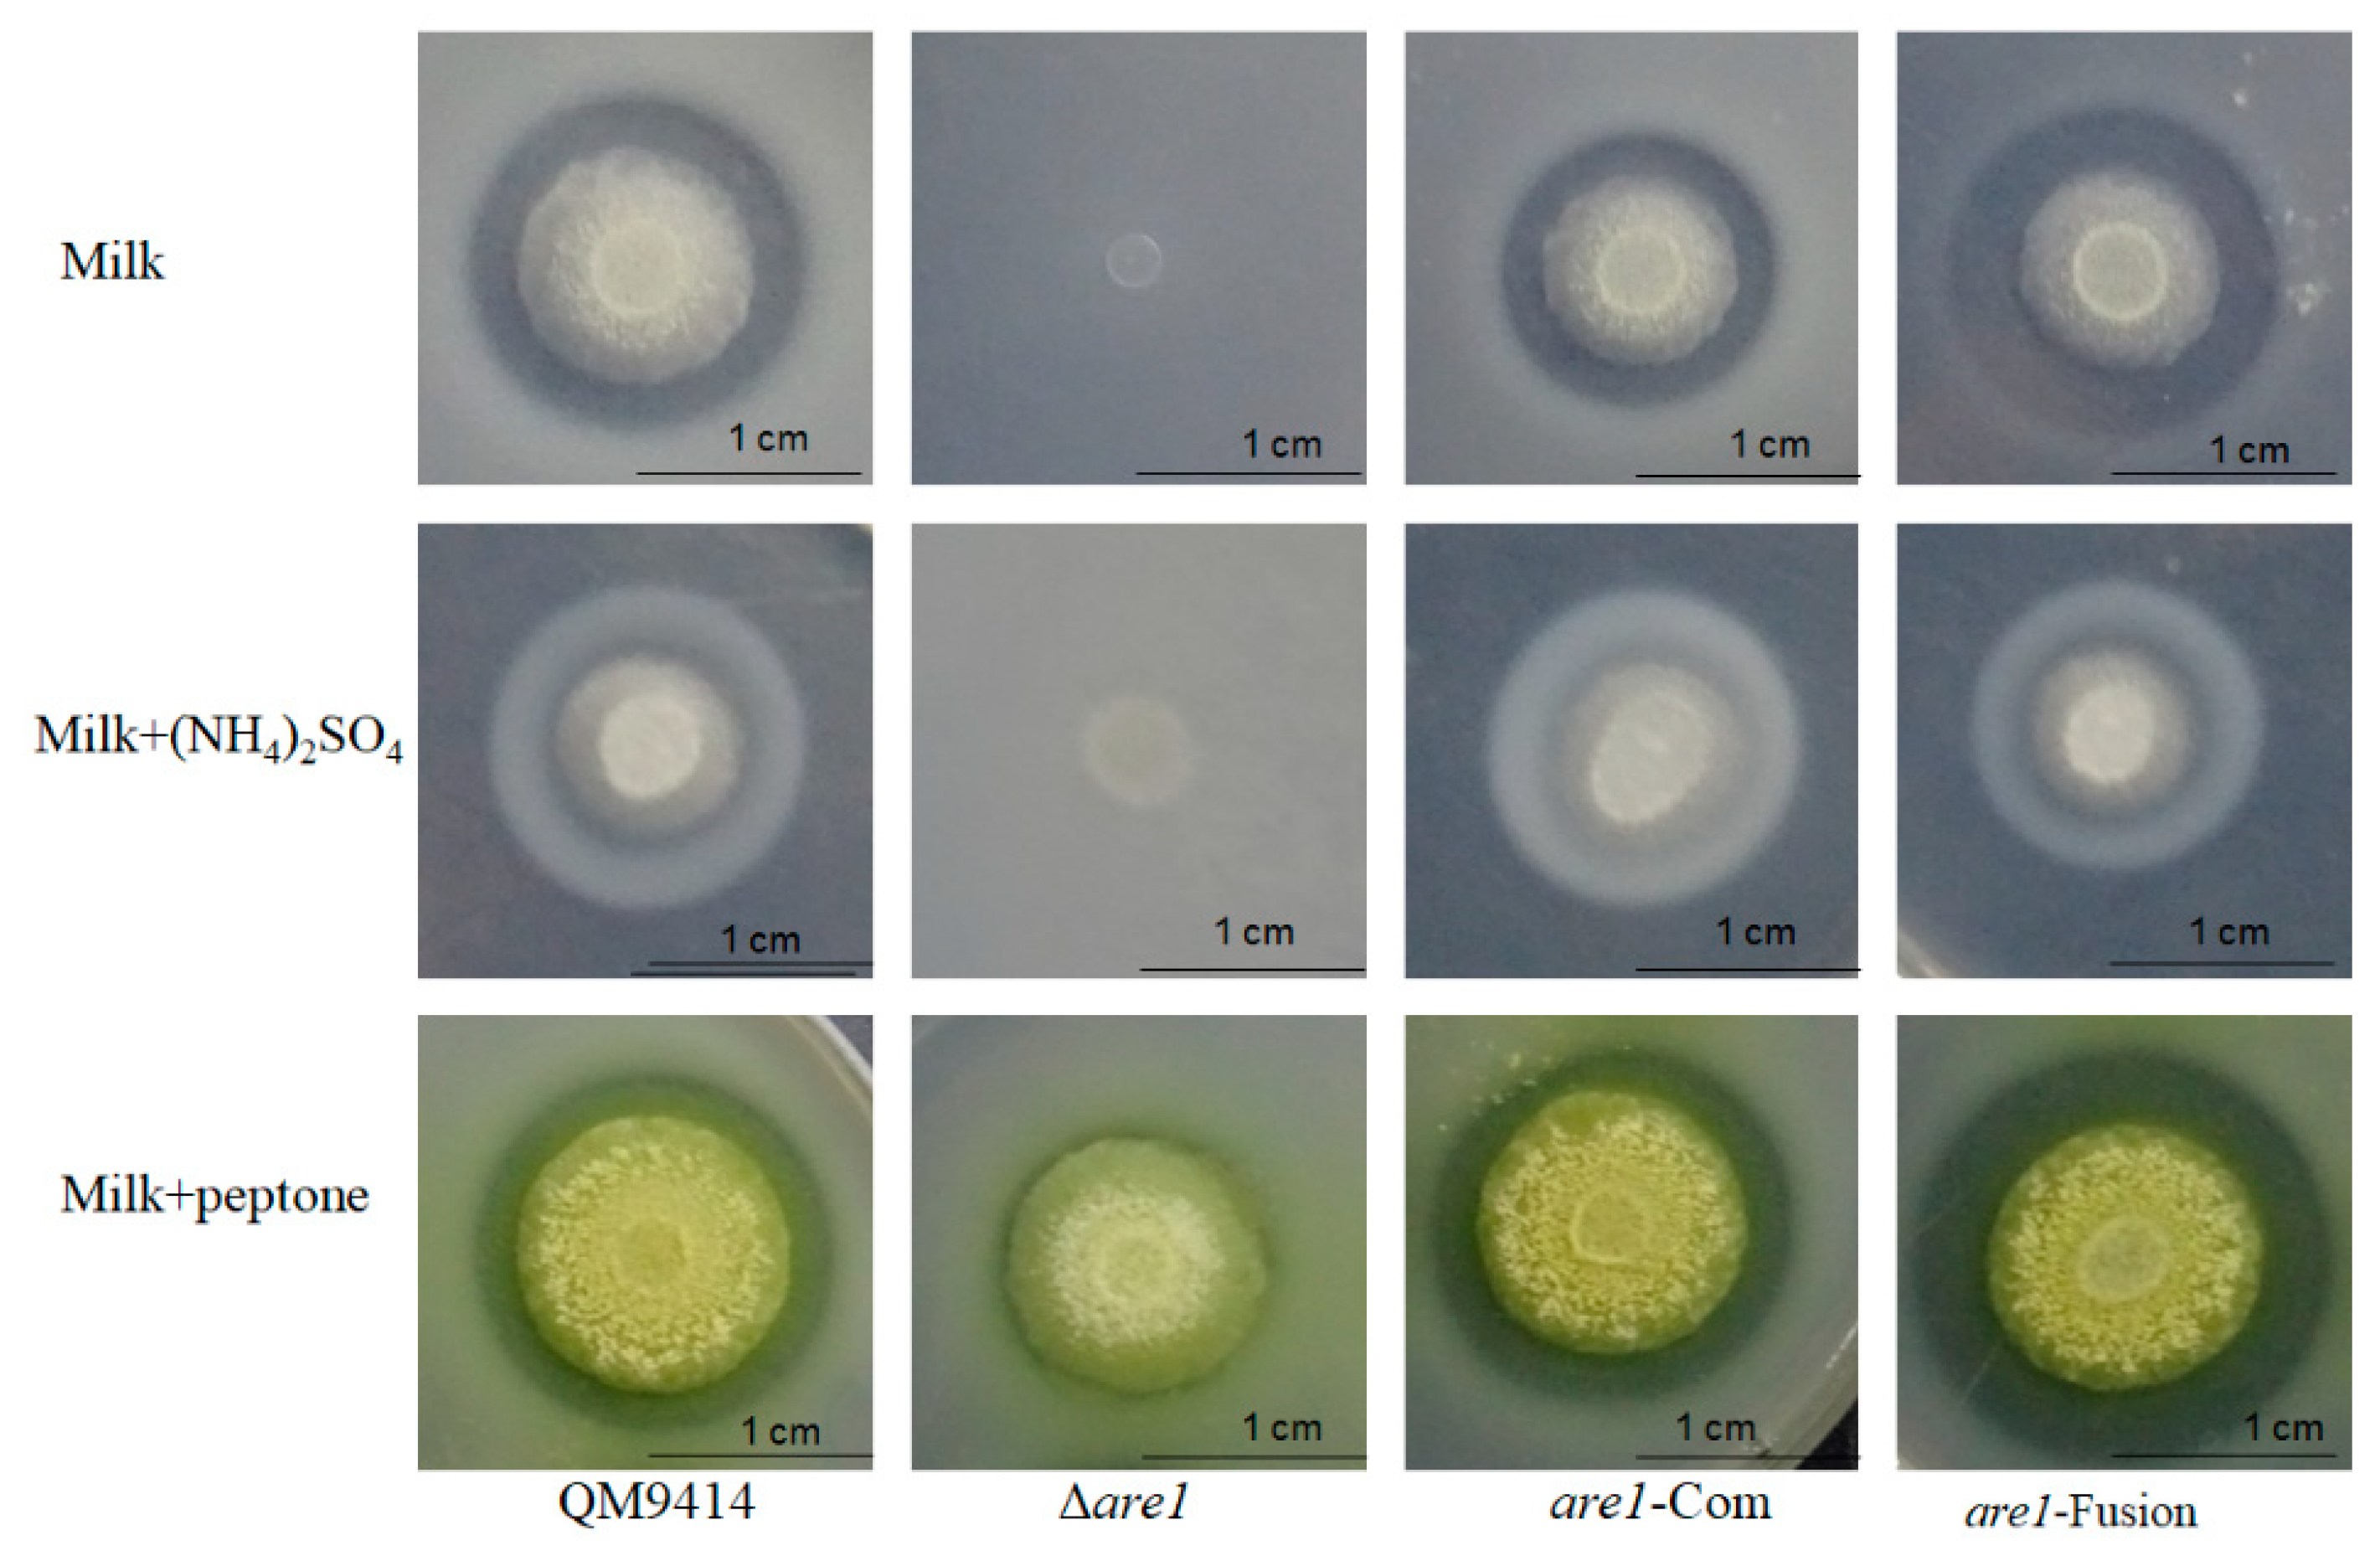
Ijms 20 04100 g003

The GATA-Type Transcriptional Factor Are1 Modulates the Expression of Extracellular Proteases and Cellulases in Trichoderma reesei
Abstract
1. Introduction
2. Results
2.1. Generation of the are1, are2, and are3 Gene-Deletion Strains in T. reesei
2.2. Disruption of are1 Abolishes Protease Production in T. reesei
2.3. Are1 is a Key Factor in Modulation of Protease Expression in T. reesei
2.4. Cellulase Production is Reduced in the Δare1 Strain
2.5. Are1 is Involved in Regulation of the Expression of Cellulases in T. reesei
3. Discussion
4. Materials and Methods
4.1. Strains and Culture Conditions
4.2. Molecular Techniques
4.3. Construction of are1, are2, and are3 Genes Deletion Strains
4.4. Complementation of are1 in the Δare1 Strain
4.5. RNA Extraction and RT-qPCR Analysis
4.6. Detection of Cellulase Activity
5. Conclusions
Supplementary Materials
Author Contributions
Funding
Acknowledgments
Conflicts of Interest
References
- Musser, R.; Farmer, E.; Pieffer, M.; Felton, G. Caterpiller salivary gland ablation technique for the classification of role of liable enzyme glucose oxidase. J. Chem. Ecol. 2004, 28, 1691–1696. [Google Scholar] [CrossRef]
- Saleemi, M.K.; Khan, M.Z.; Khan, A.; Mehmood, M.A.; Farooq, M.; Hameed, S.; Hassan, Z.U.; Javed, M.R.; Javed, I. Molecular identification of black Aspergilli isolated from poultry feeds by sequencing of its region. Pak. Vet. J. 2012, 32, 171–174. [Google Scholar]
- Zia, M.A.; Riaz, A.; Rasul, S.; Abbas, R.Z. Evaluation of antimicrobial activity of glucose oxidase from Aspergillus niger EBL-A and Penicillium notatum. Braz. Arch. Biol. Technol. 2013, 56, 956–961. [Google Scholar] [CrossRef]
- Fernandez, J.; Wright, J.D.; Hartline, D.; Quispe, C.F.; Madayiputhiya, N.; Wilson, R.A. Principles of carbon catabolite repression in the rice blast fungus: Tps1, Nmr1-3, and a MATE-family pump regulate glucose metabolism during infection. PLoS Genet. 2012, 8, e1002673. [Google Scholar] [CrossRef] [PubMed]
- Ilmen, M.; Thrane, C.; Penttila, M. The glucose repressor gene cre1 of Trichoderma: Isolation and expression of a full-length and a truncated mutant form. Mol. Gen. Genet. 1996, 251, 451–460. [Google Scholar] [CrossRef] [PubMed]
- Saloheimo, A.; Aro, N.; Ilmen, M.; Penttila, M. Isolation of the ace1 gene encoding a Cys(2)-His(2) transcription factor involved in regulation of activity of the cellulase promoter cbh1 of Trichoderma reesei. J. Biol. Chem. 2000, 275, 5817–5825. [Google Scholar] [CrossRef] [PubMed]
- Aro, N.; Pakula, T.; Penttilä, M. Transcriptional regulation of plant cell wall degradation by filamentous fungi. FEMS Microbiol. Rev. 2005, 29, 719–739. [Google Scholar] [CrossRef]
- Peij, N.V.; Gielkens, M.; Vries, R.D.; Visser, J.; Graaff, L.D. The transcriptional activator XlnR regulates both xylanolytic and endoglucanase gene expression in Aspergillus niger. Appl. Environ. Microbiol. 1998, 64, 3615–3619. [Google Scholar]
- Stricker, A.R.; Grosstessner-Hain, K.; Wurleitner, E.; Mach, R.L. Xyr1 (xylanase regulator 1) regulates both the hydrolytic enzyme system and d-xylose metabolism in Hypocrea jecorina. Eukaryot. Cell 2006, 5, 2128–2137. [Google Scholar] [CrossRef]
- Znameroski, E.A.; Coradetti, S.T.; Roche, C.M.; Tsai, J.C.; Iavarone, A.T.; Cate, J.H.D. Induction of lignocellulose-degrading enzymes in Neurospora crassa by cellodextrins. Proc. Natl. Acad. Sci. USA 2012, 109, 6012–6017. [Google Scholar] [CrossRef]
- Cao, Y.; Zheng, F.; Wang, L.; Zhao, G.; Chen, G.; Zhang, W.; Liu, W. Rce1, a novel transcriptional repressor, regulates cellulase gene expression by antagonizing the transactivator Xyr1 in Trichoderma reesei. Mol. Microbiol. 2017, 105, 65–83. [Google Scholar] [CrossRef] [PubMed]
- Gao, J.; Qian, Y.C.; Wang, Y.F.; Qu, Y.B.; Zhong, Y.H. Production of the versatile cellulase for cellulose bioconversion and cellulase inducer synthesis by genetic improvement of Trichoderma reesei. Biotechnol. Biofuels 2017, 15, 272. [Google Scholar] [CrossRef] [PubMed]
- Dos Santos Castro, L.; de Paula, R.G.; Antonieto, A.C.; Persinoti, G.F.; Silva-Rocha, R.; Silva, R.N. Understanding the role of the master regulator XYR1 in Trichoderma reesei by global transcriptional analysis. Front. Microbiol. 2016, 7, 175. [Google Scholar] [CrossRef] [PubMed]
- Antonieto, A.C.; Dos Santos Castro, L.; Silva-Rocha, R.; Persinoti, G.F.; Silva, R.N. Defining the genome-wide role of CRE1 during carbon catabolite repression in Trichoderma reesei using RNA-Seq analysis. Fungal Genet. Biol. 2014, 73, 93–103. [Google Scholar] [CrossRef] [PubMed]
- Arst, J.H.N.; Cove, D.G. Nitrogen metabolite repression in Aspergillus nidulans. Melee. Gen. Genet. 1973, 126, 111–141. [Google Scholar] [CrossRef] [PubMed]
- Fu, Y.H.; Marzluf, G.A. nit-2, the major nitrogen regulatory gene of Neurospora crassa, encodes a protein with a putative zinc finger DNA-binding domain. Mol. Cell. Biol. 1990, 10, 1056–1065. [Google Scholar] [CrossRef]
- Kudla, B.; Caddick, M.X.; Langdon, T.; Martinez-Rossil, N.M.; Bennett, C.F.; Sibley, S.; Davies, R.W.; Arst, J.H.N. The regulatory gene areA mediating nitrogen metabolite repression in Aspergillus nidulans. EMBO J. 1990, 9, 1355–1364. [Google Scholar] [CrossRef]
- Wong, K.H.; Hynes, M.J.; Todd, R.B.; Davis, M.A. Deletion and overexpression of the Aspergillus Nidulans GATA factor AreB reveals unexpected pleiotropy. Microbiology 2009, 155, 3868–3880. [Google Scholar] [CrossRef]
- Kim, H.; Woloshuk, C.P. Role of AREA, a regulator of nitrogen metabolism, during colonization of maize kernels and fumonisin biosynthesis in Fusarium verticillioides. Fungal Genet. Biol. 2008, 45, 947–953. [Google Scholar] [CrossRef]
- Ehrlich, K.C.; Cotty, P.J. Variability in nitrogen regulation of aflatoxin production by Aspergillus flavus strains. Appl. Microbiol. Biotechnol. 2002, 60, 174–178. [Google Scholar]
- Martina, M. AREA directly mediates nitrogen regulation of gibberellin biosynthesis in Gibberella fujikuroi, but its activity is not affected by NMR. Mol. Microbiol. 2003, 47, 975–991. [Google Scholar]
- Gardiner, D.M.; Kazan, K.; Manners, J.M. Novel Genes of Fusarium graminearum That Negatively Regulate Deoxynivalenol Production and Virulence. Mol. Plant Microbe Interact. 2009, 22, 1588–1600. [Google Scholar] [CrossRef] [PubMed]
- Min, K.; Shin, Y.; Son, H.; Lee, J.; Kim, J.C.; Choi, G.J.; Lee, Y.W. Functional analyses of the nitrogen regulatory gene areA in Gibberella zeae. FEMS Microbiol. Lett. 2012, 334, 66–73. [Google Scholar] [CrossRef] [PubMed]
- Muro-Pastor, M.; Gonzalez, R.; Strauss, J.; Narendja, F.; Scazzocchio, C. The GATA factor AreA is essential for chromatin remodelling in an eucaryotic bidirectional promoter. EMBO J. 1999, 18, 1584–1597. [Google Scholar] [CrossRef] [PubMed]
- Berger, H.; Basheer, A.; Bock, S.; Reyes-Dominguez, Y.; Dalik, T.; Altmann, F.; Strauss, J. Dissecting individual steps of nitrogen transcription factor cooperation in the Aspergillus nidulans nitrate cluster. Mol. Microbiol. 2008. 69, 1385–1398.
- Bi, F.; Ment, D.; Luria, N.; Meng, X.; Prusky, D. Mutation of AREA affects growth, sporulation, nitrogen regulation, and pathogenicity in Colletotrichum gloeosporioides. Fungal Genet. Biol. 2017. 99, 29–39. [CrossRef]
- Todd, R.B.; Fraser, J.A.; Wong, K.H.; Davis, M.A.; Hynes, M.J. Nuclear accumulation of the GATA factor AreA in response to complete nitrogen starvation by regulation of nuclear export. Eukaryot. Cell. 2005, 4, 1646–1653. [Google Scholar] [CrossRef] [PubMed]
- Dabas, N.; Morschhauser, J.A. transcription factor regulatory cascade controls secreted aspartic protease expression in Candida albicans. Mol. Microbiol. 2008, 69, 586–602. [Google Scholar] [CrossRef]
- Morschhäuser, J. Nitrogen regulation of morphogenesis and protease secretion in Candida albicans. Int. J. Med. Microbiol. 2011, 301, 390–394. [Google Scholar] [CrossRef]
- Lockington, R.A.; Rodbourn, L.; Barnett, S.; Carter, C.J.; Kelly, J.M. Regulation by carbon and nitrogen sources of a family of cellulases in Aspergillus nidulans. Fungal Genet. Biol. 2002, 37, 190–196. [Google Scholar] [CrossRef]
- Bugeja, H.E.; Hynes, M.J.; Andrianopoulos, A. AreA controls nitrogen source utilisation during both growth programs of the dimorphic fungus Penicillium marneffei. Fungal Biol. 2012, 116, 145–154. [Google Scholar] [CrossRef] [PubMed]
- Zhang, G.; Zhu, Y.; Wei, D.; Wang, W. Enhanced production of heterologous proteins by the filamentous fungus Trichoderma reesei via disruption of the alkaline serine protease SPW combined with a pH control strategy. Plasmid 2014, 71, 16–22. [Google Scholar] [CrossRef] [PubMed]
- Ravagnani, H.; Gorfinkiel, L.; Langdon, T.; Diallinas, G.; Adjadj, E.; Demais, S.; Gorton, D.; Arst, J.H.N.; Scazzocchio, C. Subtle hydrophobic interactions between the seventh residue of the zinc finger loop and the first base of an HGATAR sequence determine promoter-specific recognition by the Aspergillus nidulans GATA factor AreA. EMBO J. 1997, 16, 3974–3986. [Google Scholar] [CrossRef] [PubMed]
- Jun, H.; Bing, Y.; Keying, Z.; Xuemei, D.; Daiwen, C. Strain improvement of Trichoderma reesei Rut C-30 for increased cellulase production. Indian J. Microbiol. 2009, 49, 188–195. [Google Scholar] [CrossRef] [PubMed][Green Version]
- Pellier, A.L.; Laugé, R.; Veneault-Fourrey, C.; Langin, T. CLNR1 the AREA/NIT2-like global nitrogen regulator of the plant fungal pathogen Colletotrichum lindemuthianum is required for the infection cycle. Mol. Microbiol. 2003, 48, 639–655. [Google Scholar] [CrossRef] [PubMed]
- Pateman, J.A.; Dunn, E.; Kinghorn, J.R.; Forbes, E.C. The transport of ammonium and methylammonium in wild type and mutant cells of Aspergillus nidulans. Mol. Gen. Genet. 1974, 133, 225–236. [Google Scholar] [CrossRef] [PubMed]
- Yamada, T.; Makimura, K.; Abe, S. Isolation, characterization, and disruption of dnr1, the areA/nit-2-like nitrogen regulatory gene of the zoophilic dermatophyte, Microsporum canis. Med. Mycol. 2006, 44, 243–252. [Google Scholar] [CrossRef] [PubMed]
- DeBusk, R.M.; Ogilvie, S. Regulation of amino acid utilization in Neurospora crassa: Effect of nmr-l and ms-5 mutations. J. Bucteriol. 1984, 160, 656–661. [Google Scholar]
- Qian, Y.; Zhong, L.; Hou, Y.; Qu, Y.; Zhong, Y. Characterization and strain improvement of a Hypercellulytic variant, Trichoderma reesei SN1, by genetic engineering for optimized cellulase production in biomass conversion improvement. Front. Microbiol. 2016, 7, 1349. [Google Scholar] [CrossRef]
- Yu, J.H.; Hamari, Z.; Han, K.H.; Seo, J.A.; Reyes-Dominguez, Y.; Scazzocchio, C. Double-joint PCR: A PCR-based molecular tool for gene manipulations in filamentous fungi. Fungal. Genet. Biol. 2004, 41, 973–981. [Google Scholar] [CrossRef]
- Ghose, T.K. Measurement of Cellulase Activities. Pure Appl. Chem. 1987, 59, 257–268. [Google Scholar] [CrossRef]

| Primers | Sequences (5′-3′) | Employment |
|---|---|---|
| ARE1-1618-UF1 | AAGCACTGGTTGTTGGTTGG | mutant construction |
| ARE1-52-UR1 | TGCTCCTTCAATATCAGTTAAGGTCGAAGAAGGCTAATGGGGGAGAA | mutant construction |
| ARE1-232-DF1 | AAATTCCGTCACCAGCCCTGGGTTGTGATACCTGGGTCTTTTGTGTG | mutant construction |
| ARE1-1729-DR1 | TCTGGTTCCGATAGCCGA | mutant construction |
| ARE1-1522-UF2 | CCCCTGTCCGTTAGCAGTTCAT | mutant construction |
| ARE1-1426-UR2 | AGCATTTGGCATTTGCGAGAGA | mutant construction |
| Hph-F1 | CGACGTTAACTGATATTGAA | mutant construction |
| Hph-R1 | CAACCCAGGGCTGGTGACGG | mutant construction |
| ARE2 -2073-UF1 | AGGGGCACTGGCAAATAT | mutant construction |
| ARE2 -173-UR1 | GAAGCATAAAGTGTAAAGCCTGGGGGCCCGTTTTAGGCTTAGAG | mutant construction |
| ARE2-70-DF1 | ATACAAACAAAGATGCAAGAGCGGCGTGGCAACGATGGATGT | mutant construction |
| ARE2-1537-DR1 | ACCCTGAATGGTGTCCCTC | mutant construction |
| PtrA-F1 | CCCCAGGCTTTACACTTTAT | mutant construction |
| ptrA-R1 | CCGCTCTTGCATCTTTGTT | mutant construction |
| ARE3-1676-UF1 | AGGGAGGCTGTCGGAGTG | mutant construction |
| ARE3-36-UR1 | GAAGCATAAAGTGTAAAGCCTGGGGGGGCTTTTGTTGATGTTTCTC | mutant construction |
| ARE3-457-DF1 | ATACAAACAAAGATGCAAGAGCGGCCCTGTCTATTCCTGAGTGT | mutant construction |
| ARE3-1949DR1 | GGTATGAGTCGCAGGGAG | mutant construction |
| ARE3-1585-UF2 | CGAACGAAGGTGGTGGAGAT | mutant construction |
| ARE3-1415-DR2 | CCGCTTGTATGCTGGGGACT | mutant construction |
| Y-hph-121-DF1 | ACTGAGGAATCCGCTCTTGG | mutant construction |
| Y-hph-168-UR1 | ACTGCTTACAAGTGGGCTGA | mutant construction |
| Y-ptrA-UR1 | CATTGTCGGTTGGTTTGG | mutant construction |
| Y-ptrA-DF1 | ATGTAACGGTGGGGCATT | mutant construction |
| ARE1-1064-UF | TTATCGGTCAGTCTCCATCTTCA | mutant construction |
| ARE1-535-DR | TCCATTTTCCCAACATACTCCA | mutant construction |
| PgpdA-S | AGACCTAATACAGCCCCTAC | mutant construction |
| PgpdA-A | AACAGCTCCTCGCCCTTGCTCACCATATGTCTGCTCAAGCGGGGTAG | mutant construction |
| ARE1-3-F | GGCATGGACGAGCTGTACAAGGCAGCTGTCGGACCGCTT | mutant construction |
| ARE1-923-DR1 | ATGAGCCCAAGAAAGACTGAAGAG | mutant construction |
| ARE1-340-DR2 | CAGGCAGAGCAGAAAGAAATAAAAG | mutant construction |
| ARE1-1072-R | GTAGGGGCTTCTGTTCCA | mutant construction |
| ARE1-384DF | GAAGAACAGCCTCGGTGCG | probe |
| ARE1-1206DR | CTGCCTATCCCCAAGCGTC | probe |
| real-APW1-F1 | AGGCACGGACAGAACGGCAGCT | RT-qPCR for apw1 |
| real-APW1-R1 | CGTTGGCGTAGTAGGCATCG | RT-qPCR for apw1 |
| real-APW2-F1 | GCGATGTCTACCACGATATTGTCTC | RT-qPCR for apw2 |
| real-APW2-R1 | TCAAGGCTGCCGACGATGTT | RT-qPCR for apw2 |
| real-cbh1-F1 | CCGAGCTTGGTAGTTACTCTG | RT-qPCR for cbh1 |
| real-cbh1-R1 | GGTAGCCTTCTTGAACTGAGT | RT-qPCR for cbh1 |
| real-cbh2-F1 | CTGGTCCAACGCCTTCTTCA | RT-qPCR for cbh2 |
| real-cbh2-R1 | GACCCAGACAAACGAATCCAG | RT-qPCR for cbh2 |
| real-egl1-F1 | CTCAGATGGACGAGAACGGG | RT-qPCR for egl1 |
| real-egl1-R1 | CTGGTGGCTAGTGTTGAGGG | RT-qPCR for egl1 |
| real-egl2-F1 | AACAAGTCCGTGGCTCCATT | RT-qPCR for egl2 |
| real-egl2-R1 | TCCGCTCCAACCAATACCTC | RT-qPCR for egl2 |
| real-actin-F1 | CCCAAGTCCAACCGTGAGA | RT-qPCR for actin |
| real-actin-R1 | CAATGGCGTGAGGAAGAGC | RT-qPCR for actin |
© 2019 by the authors. Licensee MDPI, Basel, Switzerland. This article is an open access article distributed under the terms and conditions of the Creative Commons Attribution (CC BY) license (http://creativecommons.org/licenses/by/4.0/).
Share and Cite
Qian, Y.; Sun, Y.; Zhong, L.; Sun, N.; Sheng, Y.; Qu, Y.; Zhong, Y. The GATA-Type Transcriptional Factor Are1 Modulates the Expression of Extracellular Proteases and Cellulases in Trichoderma reesei. Int. J. Mol. Sci. 2019, 20, 4100. https://doi.org/10.3390/ijms20174100
Qian Y, Sun Y, Zhong L, Sun N, Sheng Y, Qu Y, Zhong Y. The GATA-Type Transcriptional Factor Are1 Modulates the Expression of Extracellular Proteases and Cellulases in Trichoderma reesei. International Journal of Molecular Sciences. 2019; 20(17):4100. https://doi.org/10.3390/ijms20174100
Chicago/Turabian StyleQian, Yuanchao, Yu Sun, Lixia Zhong, Ningning Sun, Yifan Sheng, Yinbo Qu, and Yaohua Zhong. 2019. "The GATA-Type Transcriptional Factor Are1 Modulates the Expression of Extracellular Proteases and Cellulases in Trichoderma reesei" International Journal of Molecular Sciences 20, no. 17: 4100. https://doi.org/10.3390/ijms20174100
APA StyleQian, Y., Sun, Y., Zhong, L., Sun, N., Sheng, Y., Qu, Y., & Zhong, Y. (2019). The GATA-Type Transcriptional Factor Are1 Modulates the Expression of Extracellular Proteases and Cellulases in Trichoderma reesei. International Journal of Molecular Sciences, 20(17), 4100. https://doi.org/10.3390/ijms20174100
